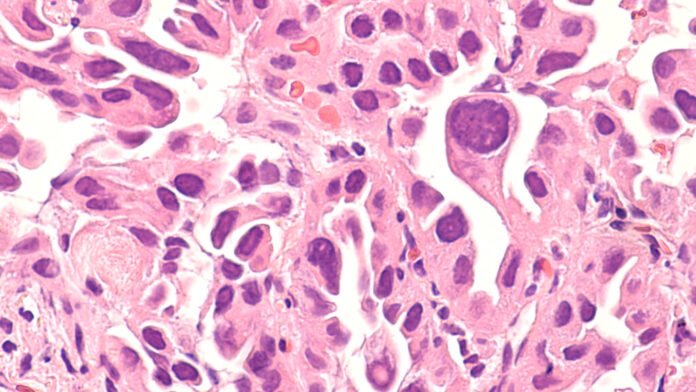

Vuoi rimanere aggiornato sulla scienza e sulla politica che guidano la biotecnologia oggi? Iscrizione per ricevere la nostra newsletter biotecnologica nella tua casella di posta.
Mattina! Oggi sentiamo parlare dei piani di un CEO di rendere pubblica la sua azienda, un giorno, dopo un pesante round di Serie F. Inoltre, assistiamo al lancio di una nuova startup sull’obesità e discutiamo di bacchette magiche.
Parabilis raccoglie 305 milioni di dollari e punta all’IPO
Parabilis Medicines, ex FogPharma, ha raccolto 305 milioni di dollari in un round di serie F per spingere il suo principale farmaco antitumorale peptidico a forma di cavatappi in studi in fase avanzata, scrive Allison DeAngelis di STAT.


Questo articolo è esclusivo per gli abbonati STAT+
Sblocca questo articolo, oltre ad analisi approfondite, newsletter, eventi premium e avvisi di notizie.
Hai già un account? Login